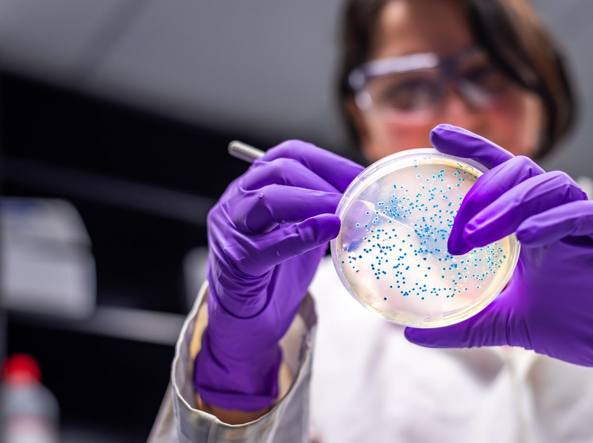

Riaprono lidi e spiagge. No alla movida che “rincretinisce i ragazzini con alcol e droga”. Via libera ad alberghi e piscine. Contagi in calo
Si alle spiagge e al mare, guerra ad alcol e droga ai ragazzini. Sono le novità che arrivano dalla Regione Campania. Ma partiamo dai numeri sempre più confortanti. I tamponi esaminati ieri nei laboratori degli ospedali della Campania sono stati 4.867, sono risultati positivi al virus 11. Ad oggi nella nostra regione le persone che si sono ammalate di Covid-19 sono 4.744 su 166.692 test effettuati. Nessun tampone è risultato positivo in quelli processati nell’ospedale di Salerno e di Eboli.
Le regole per andare al mare

Da oggi, chi vuole può andare al mare. Ma rispettando le regole, abbastanza stringenti, della recente ordinanza della Regione Campania. In particolare accesso al lido solo con prenotazione, dieci metri quadri di spazio per ogni ombrellone e almeno un metro e mezzo tra ogni lettino, sdraio o sedia. All’arrivo e fino al raggiungimento del proprio posto bisognerà indossare la mascherina e così anche all’uscita. Da dimenticare le chiacchierate a gruppo sulla battigia, è vietato perché si crea assembramento. I gestori dovranno installare dispenser per igienizzare le mani. Docce solo all’aperto.
Per le spiagge libere è compito dei Comuni adeguarle ad un uso corretto secondo un vademecum diffuso dalla Regione. Resta il distanziamento degli ombrelloni e si fa affidamento alla responsabilità dei bagnanti. Le amministrazioni comunali dovranno assicurareopportune misure di sorveglianza e pulizia della spiaggia e di igienizzazione delle attrezzature comuni, come ad esempio, se presenti, i servizi igienici. Il sindaco può arrivare anche a chiudere la spiaggia libera nel caso di rischio per la salute degli utenti a causa di assembramenti o di ripetute violazioni delle misure sanitarie di sicurezza. Via libera alla nautica da diporto anche verso le isole, solo per i residenti o domiciliati in Campania.
“Basta alcol e droga ai ragazzini”

Il governatore Vincenzo De Luca ha dichiarato guerra alla movida che “rincretinisce i giovani con l’alcol con gente senza scrupoli pronta a rovinare una generazione per 10 euro con ragazze e ragazzi di 13 anni che vanno in coma etilico e si bucano lo stomaco”. De Luca ha confermato che i baretti devono chiudere alle 23 “finché – ha detto – non avremo forme di controllo serio ed effettivo da parte delle forze dell’ordine”. Ed ha annunciato di aver chiesto al ministero dell’Interno un impegno massiccio delle forze dell’ordine. Sempre in merito della movida ha annunciato l’avvio di una campagna che chiama “Cafoni zero”: “Sarà una campagna internazionale. Dobbiamo cogliere quest’occasione per umanizzare i momenti di incontro durante la movida. Basta rumori e ammuina che non ti permettono più di ascoltare o parlare”, ha concluso De Luca.
Un’altra campagna internazionale che la Campania realizzerà è quella per riportare i turisti nella nostra regione. “Faremo – ha spiegato – una campagna di promozione turistica internazionale utilizzando il brand ‘Campania sicura’. Vogliamo spiegare che chi viene nella nostra regione viene in una terra benedetta da Dio, la ‘Campania divina’ che in questo caso diventa ‘Campania sicura’. C’è anche un calendario delle prossime riaperture. Dal 25 maggio dovrebbero riaprire gli alberghi, i B&B, i centri termali, piscine e palestre.
Soldi per la ricerca
Sul fronte della lotta al coronavirus, De Luca ha detto che la Regione investirà un fondo di 7 milioni di euro da “dare ai ricercatori per aiutare a contrastare il Coronavirus anche sul piano scientifico”.


